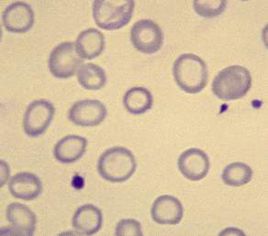

笨笨们的提问Web用户
Q
末末了儿
2025年12月07日 16:49
问题编号: 42242
患者,男,45岁。突然感觉胸痛,4小时后到医院就诊,心电图ST段抬高,以下哪项检查对于排除急性心肌梗死的首要指标
A. CK
B. CK-MB亚型
C. cTn
D. Mb
E. LDH
A. CK
B. CK-MB亚型
C. cTn
D. Mb
E. LDH
问1:所以结果是单选肌红蛋白mb嘛
Q
小花生
2025年12月07日 10:19
问题编号: 43456
在用RIA检测某种激素在血清中的浓度时,其抗原抗体复合物中放射性强度越大,表明
A.该激素在血清中的浓度越高
B.该激素在血清中的浓度越低
C.游离的标记激素的浓度越高
D.对这种激素的特异性抗体浓度越高
E.结合的标记激素的浓度越低
A.该激素在血清中的浓度越高
B.该激素在血清中的浓度越低
C.游离的标记激素的浓度越高
D.对这种激素的特异性抗体浓度越高
E.结合的标记激素的浓度越低
问1:RIA是什么试验
Q
小花生
2025年12月07日 10:16
问题编号: 43451
对于非Q波心肌梗死的确定性诊断,意义最大的是
A.CK
B.Mb
C.CK-MB
D.cTn
E.AST
A.CK
B.Mb
C.CK-MB
D.cTn
E.AST
问1:ctn是诊断哪种心肌梗死的
Q
爱跳舞的Nancy
2025年12月06日 21:05
问题编号: 38008
培养基的质量控制不包括
A.配制好的培养基随机抽取5%~10%的量做无菌试验
B.MH平板的厚度应为4mm,其他平板厚度一般为3mm
C.配制好的培养基pH应与规定的pH相差±0.2以内
D.一般平板培养基2~8℃可贮存1~2周,兔血平板至多保存一周
E.均应用已知性质的标准菌株进行预测,合格者方可使用
A.配制好的培养基随机抽取5%~10%的量做无菌试验
B.MH平板的厚度应为4mm,其他平板厚度一般为3mm
C.配制好的培养基pH应与规定的pH相差±0.2以内
D.一般平板培养基2~8℃可贮存1~2周,兔血平板至多保存一周
E.均应用已知性质的标准菌株进行预测,合格者方可使用
问1:我觉得正确答案应该是E,A选项应该是培养基质量控制最重要的
Q
黄伟芬
2025年12月06日 10:33
问题编号: 28338
血涂片镜检如图2所示,剪头所指的是

A.红细胞裂片
B.口形红细胞
C.球形红细胞
D.靶形红细胞
E.低色素红细胞

A.红细胞裂片
B.口形红细胞
C.球形红细胞
D.靶形红细胞
E.低色素红细胞
问1:这个箭头在哪里
Q
可爱
2025年12月06日 00:50
问题编号: 40124
下图为血清蛋白的免疫固定电泳,最可能的疾病是

A.肾病综合症
B.多发性骨髓瘤
C.浆细胞白血病
D.巨球蛋白血症
E.肝硬化

A.肾病综合症
B.多发性骨髓瘤
C.浆细胞白血病
D.巨球蛋白血症
E.肝硬化
问1:如何分析上图中的免疫固定电泳呢?不会看
Q
小花生
2025年12月03日 20:57
问题编号: 41776
下列哪种多肽激素与所列的其他激素无结构的类似性
A.TSH
B.LH
C.GC
D.hCG
E.FSH
A.TSH
B.LH
C.GC
D.hCG
E.FSH
问1:GC是什么
Q
lgy
2025年12月03日 16:09
问题编号: 42686
有关特种蛋白的叙述,正确的是
A.转铁蛋白含铜
B.a1-抗胰蛋白酶具有氧化酶活性
C.a2-球蛋白是营养指标
D.血红素结合蛋白能结合血红蛋白
E.a1-酸性糖蛋白是急性时相反应蛋白
A.转铁蛋白含铜
B.a1-抗胰蛋白酶具有氧化酶活性
C.a2-球蛋白是营养指标
D.血红素结合蛋白能结合血红蛋白
E.a1-酸性糖蛋白是急性时相反应蛋白
问1:急性是反应蛋白不应该是C反应蛋白?
Q
lgy
2025年12月02日 08:53
问题编号: 42796
患者女,25岁。1年来面色苍白伴倦怠、耳鸣就诊,家族中无类似贫血史。检验:RBC 2.5X10^12/L,Hb 55g/L, MCV 75fl,MCH 22pg,MCHC 290g/L,血象如图所示,网织红细胞1.5%。为明确诊断,首选的检查是
A.骨髓铁染色
B.铁代谢检查
C.血红蛋白电泳
D.骨髓涂片检查
E.红细胞叶酸测定
问1:骨髓铁染色?
Q
末末了儿
2025年12月01日 23:20
问题编号: 29501
下列哪种病原体在AIDS病人粪便中可检出并可导致严重腹泻
A.鞭毛虫
B.纤毛虫
C.隐孢子虫
D.阿米巴原虫
E.血吸虫
A.鞭毛虫
B.纤毛虫
C.隐孢子虫
D.阿米巴原虫
E.血吸虫
问1:AIDS病人
Q
lgy
2025年12月01日 16:44
问题编号: 41182
下列哪种疾病是非器官特异性自身免疫疾病
A.重症肌无力
B.慢性甲状腺炎
C.慢性溃疡性结肠炎
D.系统性红斑狼疮
E.特发性血小板减少性紫瘢
A.重症肌无力
B.慢性甲状腺炎
C.慢性溃疡性结肠炎
D.系统性红斑狼疮
E.特发性血小板减少性紫瘢
问1:系统性红斑狼疮?
Q
圆圆圈圈
2025年11月30日 00:08
问题编号: 29911
患者男,36岁。临床诊断为慢性前列腺炎,经过一段时间的治疗后,前往医院复查,前列腺直接涂片结果无异常,此前列腺液体颜色应为
A.无色
B.乳白色
C.灰白色
D.黄色
E.红色
A.无色
B.乳白色
C.灰白色
D.黄色
E.红色
问1:之前前列腺炎,现在正常了,题目问的此前是什么样,不是现在,不应该是炎症时期吗
Q
圆圆圈圈
2025年11月29日 22:27
问题编号: 29783
采集和处理关节腔积液,正确的是
A.通常采集1-3管
B.一般无须观察凝固现象
C.第一管做性状和微生物检查
D.第二管加EDTA抗凝作化学检查
E.第三管加双草酸盐抗凝作细胞检查
A.通常采集1-3管
B.一般无须观察凝固现象
C.第一管做性状和微生物检查
D.第二管加EDTA抗凝作化学检查
E.第三管加双草酸盐抗凝作细胞检查
问1:A为啥错?
Q
皓哥锴弟
2025年11月29日 20:31
问题编号: 41253
在室内质量控制中,对随机误差检出敏感的规则是
A.13s
B.22s
C.41s
D.10x
E.连续三个质控结果中有两个同时超出+2s或-2s
A.13s
B.22s
C.41s
D.10x
E.连续三个质控结果中有两个同时超出+2s或-2s
问1:这题还是理解不清题目意思
Q
13733776372
2025年11月29日 13:07
问题编号: 43491
下列各组结果最有可能诊断为呼吸性酸中毒的是
A.pH下降,PCO2,升高,HCO3-,升高
B.pH下降,PCO2,升高,HCO3-降低
C.pH下降,PCO2,降低,HCO3-降低
D.pH升高,PCO2,降低,HCO3-升高
E.pH升高,PCO2,升高,HCO3-降低
A.pH下降,PCO2,升高,HCO3-,升高
B.pH下降,PCO2,升高,HCO3-降低
C.pH下降,PCO2,降低,HCO3-降低
D.pH升高,PCO2,降低,HCO3-升高
E.pH升高,PCO2,升高,HCO3-降低
问1:HCO3-不是应该下降?
Q
19984079271
2025年11月28日 16:29
问题编号: 28640
关于ABO血型鉴定的叙述,错误的是()。
A.先加血清然后再加红细胞悬液
B.玻片法反应时间不能少于10分钟
C.溶血与红细胞凝集意义相同
D.最适温度为37℃
E.正.反定型结果一致才可发报告
A.先加血清然后再加红细胞悬液
B.玻片法反应时间不能少于10分钟
C.溶血与红细胞凝集意义相同
D.最适温度为37℃
E.正.反定型结果一致才可发报告
问1:请解释一下C选项
Q
19984079271
2025年11月28日 15:45
问题编号: 28589
缺铁性贫血治疗有效,其红细胞直方图特点是
A.双峰出现,底变窄
B.双峰出现,底边宽
C.峰左移,底边宽
D.峰左移,底变窄
E.峰右移,底变窄
A.双峰出现,底变窄
B.双峰出现,底边宽
C.峰左移,底边宽
D.峰左移,底变窄
E.峰右移,底变窄
问1:希望解释清楚一点,治疗有效不是证明红细胞体积趋于正常、大小不一的程度变小吗,为什么底部还会增宽
Q
可爱
2025年11月27日 08:43
问题编号: 39498
与II型超敏反应无关的成分是
A.IgM/IgG
B.补体
C.NK细胞
D.吞噬细胞
E.IgE
A.IgM/IgG
B.补体
C.NK细胞
D.吞噬细胞
E.IgE
问1:老师,IgE参与几型反应?
Q
17613922905
2025年11月25日 16:04
问题编号: 28241
血液标本4℃保存,可使血液分析仪
A.红细胞计数结果减低
B.红细胞分布宽度增加
C.血小板计数结果增加
D.血小板计数结果减低
E.白细胞计数结果减低
A.红细胞计数结果减低
B.红细胞分布宽度增加
C.血小板计数结果增加
D.血小板计数结果减低
E.白细胞计数结果减低
问1:为什么
Q
lgy
2025年11月24日 22:23
问题编号: 41404
患者女,32岁。四肢近端肌肉疼痛、乏力,眼睑部皮疹3个月。CK及CK-MM明显增高。肌电图提示肌源性损害,肌肉活检见肌横纹消失,肌纤维间可见炎症细胞,该患者最可能的诊断是
A.系统性硬化症
B.皮肌炎
C.干燥综合征
D.内风湿关节炎
E.系统性血管炎
A.系统性硬化症
B.皮肌炎
C.干燥综合征
D.内风湿关节炎
E.系统性血管炎
问1:皮肌炎?
Q
可爱
2025年11月24日 22:01
问题编号: 39340
如图所示,最可能的急性白血病类型为

A.M0
B.M1
C.M2
D.M3
E.M7

A.M0
B.M1
C.M2
D.M3
E.M7
问1:没有图?如何分析?
Q
皓哥锴弟
2025年11月24日 13:22
问题编号: 41105
患者女,在一次不洁性交后出现子宫颈红肿、阴道分泌物增多、排尿困难等症状,医生怀疑为淋球菌感染。取分泌物形细菌学检查,应选择的培养基为
A.血平板培养基
B.普通琼脂糖培养基
C.SS培养基
D.巧克力培养基
E.L-j培养基
A.血平板培养基
B.普通琼脂糖培养基
C.SS培养基
D.巧克力培养基
E.L-j培养基
问1:SS培养基的全程
Q
lgy
2025年11月21日 22:03
问题编号: 41509
患者女,36岁,乏力,面试苍白半个月,半个月以来无原因进行性面色苍白、乏力,稍动则气慌,气短,尿色如浓茶,查体:贫血貌,无皮疹和出血点。实验室检查:血HB 68g/L,WBC 6.4 X10^9/L,PLT 140X10^9/L,网织红细胞 18%,尿胆原强阳性,大便隐血(—),Coombs试验(+),此患者属于
A.I型超敏反应
B.II型超敏反应
C.III型超敏反应
D.IV型超敏反应
E.不是超敏反应
A.I型超敏反应
B.II型超敏反应
C.III型超敏反应
D.IV型超敏反应
E.不是超敏反应
问1:2型超敏反应?
Q
lgy
2025年11月21日 15:17
问题编号: 42395
患者女,34岁。中度贫血,骨髓显示增生明显活跃,有核红细胞比例占41%,以晚幼红细胞为主,易见“炭核样”晚幼红细胞。成熟红细胞大小不等,以小细胞为主。为明确诊断,应首选的组化染色是
A.过氧化物酶染色
B.糖原染色
C.碱性磷酸酶积分
D.细胞内外铁染色
E.非特异性酯酶染色
A.过氧化物酶染色
B.糖原染色
C.碱性磷酸酶积分
D.细胞内外铁染色
E.非特异性酯酶染色
问1:细胞内外铁染色?
Q
13733776372
2025年11月20日 11:17
问题编号: 46538
巨球蛋白血症的特点是
A. 疾病进展迅速
B. 肝脾肿大比较常见
C. 骨骼破坏、骨痛或骨折常见
D. 由反转录病毒感染引起的
E. 为免疫增殖性疾病的良性病变
A. 疾病进展迅速
B. 肝脾肿大比较常见
C. 骨骼破坏、骨痛或骨折常见
D. 由反转录病毒感染引起的
E. 为免疫增殖性疾病的良性病变
问1:咱的答案怎么没有这个选项呢
Q
13733776372
2025年11月20日 11:15
问题编号: 46123
患儿,女,10岁。发热、头痛伴咽痛1d,体温39℃,面红,全身瘙痒,皮肤可见到弥漫鲜红色充血性针尖大小的红色细小丘疹,扁桃体红,取咽拭子可以看到G+球菌。引起本病的病原菌是
A. A群链球菌
B. B群链球菌
C. C群链球菌
D. D群链球菌
E. G群链球菌
A. A群链球菌
B. B群链球菌
C. C群链球菌
D. D群链球菌
E. G群链球菌
问1:两个A选项?
Q
13733776372
2025年11月20日 11:12
问题编号: 46566
从腹腔感染患者腹腔液中分离一革兰阴性杆菌,氧化酶阴性,苯丙氨酸脱氨酶阳性,在血平板上有迁徙生长,H2S阳性,它可能是
A. 变形杆菌
B. 摩根菌
C. 普罗威登菌
D. 伤寒沙门菌
E. 枸橼酸杆菌
A. 变形杆菌
B. 摩根菌
C. 普罗威登菌
D. 伤寒沙门菌
E. 枸橼酸杆菌
问1:没有H选项啊
Q
李思
2025年11月19日 08:19
问题编号: 39303
患者男,81岁。进行性排尿困难2年。直肠指诊触及前列腺侧叶增大、中间沟坪,左侧叶有硬结。实验室检查PSA为60ug/L,可用作此患者鉴别诊断的首选生化指标是
A.ACP
B.AFP
C.AMG
D.f-PSA/t-PSA
E.β2-M
A.ACP
B.AFP
C.AMG
D.f-PSA/t-PSA
E.β2-M
问1:到底选那个?
Q
lgy
2025年11月12日 22:21
问题编号: 44143
患者女,40岁。因半年来体重下降20多斤而就诊。无明显多饮,多食,多尿,无心慌,气短,多汗,怕热,烦躁。既往体健。无药物过敏史。个人史及家庭史无特殊。查体:T36‘C,P80次/分,R18次/分,BP120/80mmHg。查体未见异常。实验室检查:HB120g/L,WBC7.6X109/L,PLT267X109/L。尿常规:尿蛋白(-),尿糖(++),空腹血糖10.7mmol/L。最可能的诊断是
A.甲状腺功能亢进
B.恶性肿瘤
C.1型糖尿病
D.2型糖尿病
E.胰岛细胞瘤
A.甲状腺功能亢进
B.恶性肿瘤
C.1型糖尿病
D.2型糖尿病
E.胰岛细胞瘤
问1:甲状腺功能亢进?
Q
lgy
2025年11月12日 22:20
问题编号: 44141
患者男,48岁,因严重胸痛发作3小时就诊。心绞痛病史1年,心电图无异常。最可能的诊断是
A.心肌炎
B.急性肝炎
C.急性冠脉综合征
D.心功能衰竭
E.高血压
A.心肌炎
B.急性肝炎
C.急性冠脉综合征
D.心功能衰竭
E.高血压
问1:急性冠状动脉综合用
Q
林妹妹
2025年11月12日 21:32
问题编号: 39565
一份脓液标本,用20%KOH涂片后镜检,可见厚壁酵母细胞,细胞内可见脂肪小滴,可疑为
A.杜波组织胞浆菌
B.荚膜组织胞浆菌
C.申克孢子丝菌
D.卡氏肺孢菌
E.白假丝酵母菌
A.杜波组织胞浆菌
B.荚膜组织胞浆菌
C.申克孢子丝菌
D.卡氏肺孢菌
E.白假丝酵母菌
问1:不是E选项符合吗?
Q
林妹妹
2025年11月12日 21:23
问题编号: 39550
单克隆丙种球蛋白血症血清蛋白区带电泳中,IgG型M蛋白多位于
A.快γ区与β区
B.α区至慢γ区
C.β2或α区
D.β或γ区
E.β或α区
A.快γ区与β区
B.α区至慢γ区
C.β2或α区
D.β或γ区
E.β或α区
问1:不是选项D符合吗?
Q
lgy
2025年11月11日 22:15
问题编号: 43275
男性,60岁,主诉全身无力、疼痛,体重下降和多尿。体格检查有轻度面色苍白。尿白细胞4-8个/HP,尿糖(-),尿蛋白(+),尿培养(-),尿蛋白排出量2.2g/24h。为明确病因,可进行的辅助检查
A.尿蛋白电泳及尿本周蛋白分析
B.胸部X线片
C.浓缩稀释试验
D.OGTT
E.肾活检
A.尿蛋白电泳及尿本周蛋白分析
B.胸部X线片
C.浓缩稀释试验
D.OGTT
E.肾活检
问1:尿蛋白电泳及尿本周蛋白分析
Q
lgy
2025年11月11日 22:06
问题编号: 43260
试带法测尿亚硝酸盐,错误的是
A.尿液有硝酸盐
B.致病菌含有硝酸盐还原酶
C.尿液停留于膀胱足够时间
D.是尿路细菌感染的快速筛选试验
E.阴性结果能排出菌尿
A.尿液有硝酸盐
B.致病菌含有硝酸盐还原酶
C.尿液停留于膀胱足够时间
D.是尿路细菌感染的快速筛选试验
E.阴性结果能排出菌尿
问1:阴性结果能排出菌尿
Q
可爱
2025年11月11日 10:35
问题编号: 39007
患者男,26岁,高热1周,治疗效果不佳,外周血涂片显示白细胞总数和中性粒细胞数均增加,其中杆状核粒细胞≻10%,并有少量晚幼粒细胞及中毒性改变,其核像改变的类型为
A.核右移
B.中度核右移
C.轻度核左移
D.中度核左移
E.重度核左移
A.核右移
B.中度核右移
C.轻度核左移
D.中度核左移
E.重度核左移
问1:如何区分核左移或右移
Q
13733776372
2025年11月11日 09:58
问题编号: 46048
血小板表达的纤维蛋白原受体糖蛋白是
A. GPⅡb/Ⅲa
B. GPIb/IX
C. GPIa/Ⅱa
D. GPV
E. GPIV
A. GPⅡb/Ⅲa
B. GPIb/IX
C. GPIa/Ⅱa
D. GPV
E. GPIV
问1:AD选项不一样?
Q
lgy
2025年11月10日 22:20
问题编号: 41685
患者男,66岁,因上腹部疼痛4小时入院。查体:T35.2°C,P48次/分,R12次/分,血压100/80mmHg。实验室检查:WBC15.6x109/L,中性占80%,淋巴占18%,单核占2%,cTnl1.0μg/L,尿淀粉酶200U/L。最可能的诊断是
A.急性心肌梗死
B.急性肾功能衰竭
C.急性胰腺炎
D.急性胆囊炎
E.急性肠梗阻
A.急性心肌梗死
B.急性肾功能衰竭
C.急性胰腺炎
D.急性胆囊炎
E.急性肠梗阻
问1:上腹疼痛,尿淀粉酶200U/L,肯定是急性胰腺炎,不可能是急性心肌梗死
Q
鞠
2025年11月10日 19:51
问题编号: 38750
有关多发性骨髓瘤的描述,正确的是
A.嗜酸细胞恶性增生,血淸中Ig水平降低
B.嗜酸细胞恶性增生,血淸中Ig水平升高
C.浆细胞恶性增生,血淸中Ig水平升高
D.浆细胞恶性增生,血及尿中出现M蛋白
E.浆细胞恶性增生,骨髄分类正常
A.嗜酸细胞恶性增生,血淸中Ig水平降低
B.嗜酸细胞恶性增生,血淸中Ig水平升高
C.浆细胞恶性增生,血淸中Ig水平升高
D.浆细胞恶性增生,血及尿中出现M蛋白
E.浆细胞恶性增生,骨髄分类正常
问1:多发性骨髓瘤